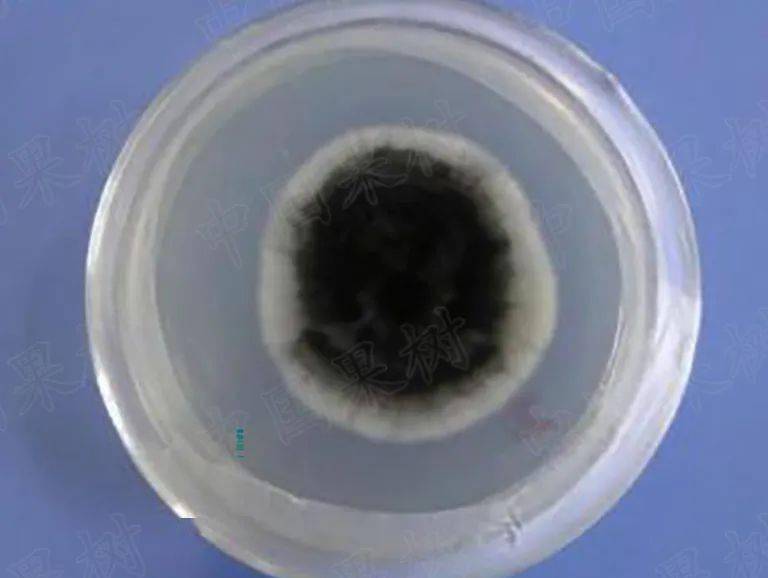
黑斑病菌落及孢子形态特征病原菌为链格孢,属于半知菌亚门丝孢纲丝梗

黑斑病菌

梨黑斑病防治是个技术活,学会以下几点,或许让你省很多心!
图片尺寸640x512
酵素农业技术酵素菌肥在作物黑斑病病害防治上的应用
图片尺寸1266x884
十字花科蔬菜及油菜黑斑病的3种致病病原菌分生孢子形态
图片尺寸2736x3648
大豆链格孢黑斑病(疾病)
图片尺寸400x309
黑斑病菌落及孢子形态特征病原菌为链格孢,属于半知菌亚门丝孢纲丝梗
图片尺寸817x612
芒果细菌性黑斑病
图片尺寸413x343
月季黑斑病专用药兰花多菌菌灵杀菌剂花卉花药多肉多菌灵白粉病药
图片尺寸760x760
一组十字花科蔬菜黑斑病图片
图片尺寸550x413
黑斑病菌落及孢子形态特征病原菌为链格孢,属于半知菌亚门丝孢纲丝梗
图片尺寸768x578
黑斑病菌落及孢子形态特征病原菌为链格孢,属于半知菌亚门丝孢纲丝梗
图片尺寸967x719
十字花科蔬菜黑斑病
图片尺寸600x400
月季头号病害黑斑病
图片尺寸1080x1440
芒果细菌性黑斑病
图片尺寸550x341
黄瓜链隔菌黑斑病与霜霉病混发图片及菌丝孢子看来还是不能相信眼睛
图片尺寸1920x902
一组十字花科蔬菜黑斑病图片
图片尺寸550x413
核桃黑斑病介绍 一, 病害症状 核桃黑斑病是细菌性病害,又叫黑腐病,是
图片尺寸600x450
前沿科技 | 中科院科学家研究鉴定并发表三种猕猴桃真菌性黑斑病,褐斑
图片尺寸640x499
月季花黑斑病农药兰花玫瑰花卉植物药多菌菌灵农药杀菌剂白粉病己唑嘧
图片尺寸800x800
产挥发性气体拮抗甘薯黑斑病菌的菌株及其应用的制作方法
图片尺寸946x930
月季花黑斑病专用药兰花多肉花药多菌菌灵农药剂多菌灵白粉病60g
图片尺寸350x350